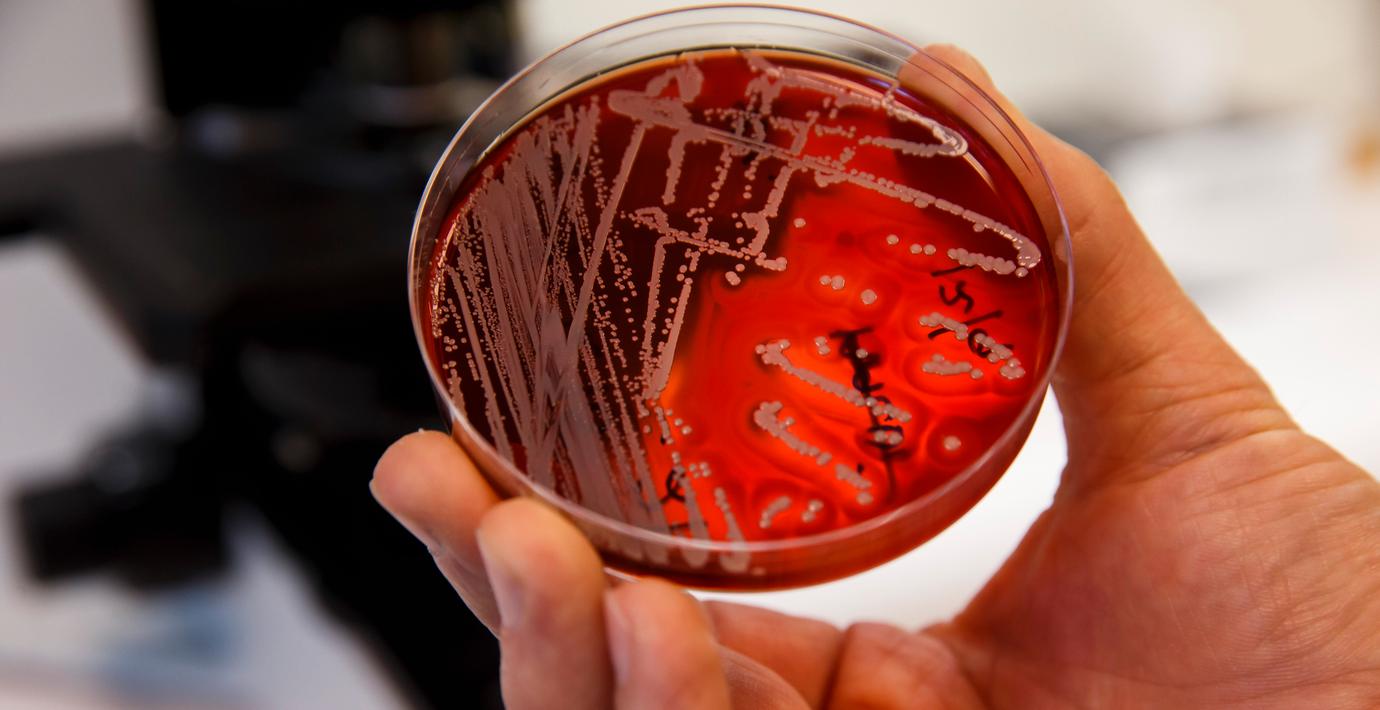

Forskare manar till snabba satsningar mot resistensen
Miljontals fler människor väntas dö årligen till följd av multiresistenta bakterier år 2050. Det visar en ny studie från tankesmedjan Center for global development som har finansierats av den brittiska regeringen, skriver The Guardian.
Anledningen är den allt mer utbredda antibiotikaresistensen. Förutom fler dödsfall väntas kostnaderna bli höga, bland annat till följd av många och långa sjukhusinläggningar.
– Att investera i behandling av bakteriella infektioner nu kommer att rädda liv och ge miljarder i långsiktiga ekonomiska vinster, säger Anthony McDonnell, som har lett studien.
Omni är politiskt obundna och oberoende. Vi strävar efter att ge fler perspektiv på nyheterna. Har du frågor eller synpunkter kring vår rapportering? Kontakta redaktionen



